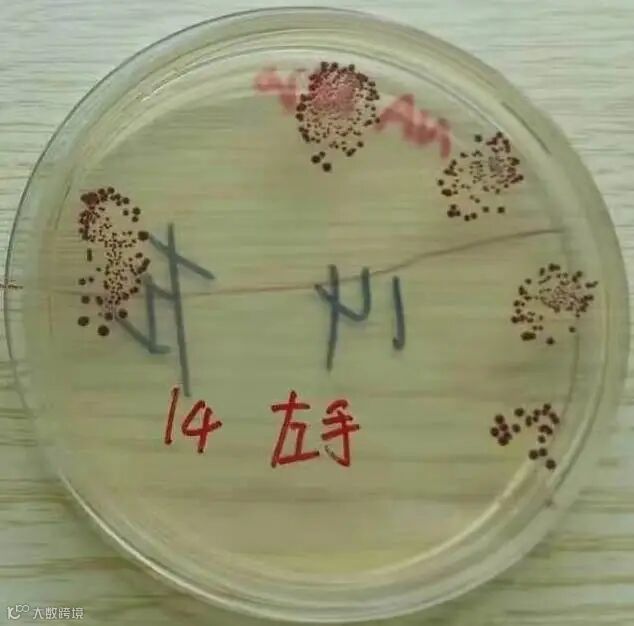
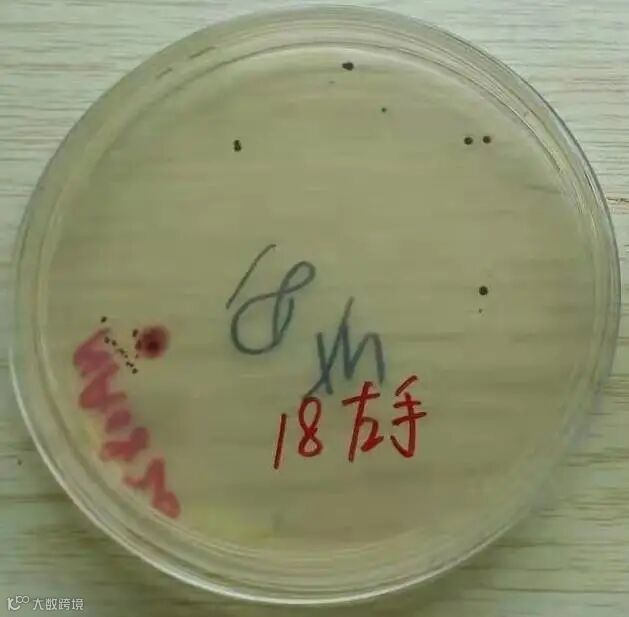

点击上方卡片关注我们
# 勤洗手

最近疫情反复,
大家一定要做好自我防护!
戴口罩、勤洗手是两个最基本也是最重要的防护措施。
消毒产品
抗菌/抑菌
关于“勤洗手”是我们最习惯不过的日常,但它却对控制疫情传播起着至关重要的效果,所以市面上各类肥皂、消毒湿巾、洗手液五花八门,它们是否都是有效抗菌抗病毒呢?我们到底该如何挑选呢?
附正确洗手“七步法”







(图片来源“健康佛山”公众号)
小编接下来给大家看一个简单的小实验:准备四个显色平板,让清洁度不同的手部按压触摸,然后再将平板放置培养,观察48小时后的情况。
未经清洗过的手
经消毒洗手液清洗10秒后的手

经消毒洗手液清洗30秒后的手

经消毒洗手液清洗2分钟后的手
培养后可以明显看到未经清洗的手和经洗手液接触10秒和30秒的触摸后的手都是出现了长菌的现象,而洗手液作用两分钟以上的的手触摸的平板是没有长菌的。
实验让我们意识到,并不是用了洗手液之后手就能完全无菌,洗手时间不同和正确洗手是非常关键的因素!勤洗手,会洗手不仅是维持个人健康的好习惯,也是预防疾病传播的重要措施!
洗手液的秘密
无论在家还是在公共场合,洗手的标配基本都是洗手液。大多数的洗手液都宣称自己强效的抑菌99.9%,看起来很厉害,会让人觉得洗手液会非常干净。


但实际上,这里存在几个误区蒙蔽了大家的双眼
抑菌并不是杀菌(抗菌)。抑菌是用化学或者物理方法抑制或妨碍细菌的生长,而并不一定能将细菌杀死,大多数的洗手液宣传的仅仅是抑菌的效果。

抑菌99.9%但实际测试的并不是全部的细菌,也不可能是全部的细菌。
一般实验室进行测试的是金黄色葡萄球菌、大肠杆菌和白色念珠菌,所以其强效的抑菌作用是对这几种菌起效果,对芽孢类或病毒活性的抑制作用是未知。

有些洗手液上会标注,在试验条件下作用2分钟可以达到抑菌99.9%的效果。


虽然标准方法和使用方法是这样规定的,但实际上我们平时洗手是达不到2分钟的,一般30秒内就结束战斗了,洗手液还没有完全发挥作用就被冲洗掉了。
正确挑选和正确使用洗手液才能达到清洁手的效果。所以我们不仅要挑选合格的洗手液,最重要的还要根据洗手液产品使用说明书标注的抑菌作用时间去正确洗手,这样我们的洗手才不会变成“假动作”,才能真正的把细菌和病毒从手上“赶走”。
疫情未停,注意防护
●
○
END
-转载请注明出处-
供稿:中纺联检(佛山)技术部 周青青
部分图片:来源网络
编辑:中纺联检(佛山)刘泽姿




